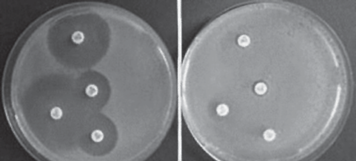

A isomerização é um fenômeno químico que permite a transformação de um hidrocarboneto em outro, como, normalmente, acontece com um composto de cadeia linear que resulta em seu isômero de cadeia ramificada. Um recipiente de 1 L contém, em equilíbrio, 1 mol de pentano e 2,5 mols de 2-metilbutano, que são dois isômeros. Considere fixa a temperatura do sistema.

Após a adição de 3 mols de pentano ao sistema citado, a concentração de 2-metilbutano, em mol/L, depois de o equilíbrio ser restabelecido será de, aproximadamente,
A isomerização é um fenômeno químico que permite a transformação de um hidrocarboneto em outro, como, normalmente, acontece com um composto de cadeia linear que resulta em seu isômero de cadeia ramificada. Um recipiente de 1 L contém, em equilíbrio, 1 mol de pentano e 2,5 mols de 2-metilbutano, que são dois isômeros. Considere fixa a temperatura do sistema.

Após a adição de 3 mols de pentano ao sistema citado, a concentração de 2-metilbutano, em mol/L, depois de o equilíbrio ser restabelecido será de, aproximadamente,